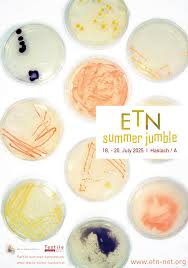
ETN summer jumble

-

DRS 2026
-

IASDR Conference
-

Unlearning Design
-

TEDxKollerschlag
-

Ars Electronica Festival 2025
-

LearnXDesign Conference
-
ETN summer jumble
-

Growing Colours. Living Pigments
-

Textile Design Futures Symposium
-

Creating new materials with bacteria and robots
-

Ars Electronica Festival 2024
-

Design Research Society Conference
-

Textile Design Now
-

Textile Intersections Conference
-

SPCS talk vol.2 – Textile Dyeing with Bacteria – Letting Nature Design
-

Es lebt. Konstruktionsmaterialien aus Pilzmyzel
-

Conversation with: Anna Blumenkranz
-

Conversation with: Jesse Howard
-

Conversation with: Taylor Levy
-

Conversation with: Precious Plastic
-

Designing not Knowing